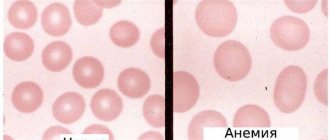

Что такое фолиеводефицитная анемия? Ее причины и факторы риска развития заболевания
Фолиеводефицитная анемия – это вид анемии (малокровия), вызываемой недостатком фолиевой кислоты, которую еще называют витамином В9. Она необходима для образования новых клеток. В первую очередь при нехватке фолиевой кислоты снижаются темпы формирования красных кровяных телец (эритроцитов) и развивается анемия как результат недостатка гемоглобина.
Основные причины дефицита витамина В9:
- недостаточное потребление фолиевой кислоты с пищей. Её много в брокколи, брюссельской капусте, горохе, нуте, коричневом рисе, артишоках. Чаще всего от дефицита В9 страдают те, кто злоупотребляет алкоголем;
- мальабсорбция – нарушение всасывания питательных веществ. В основном такое явление наблюдается при заболеваниях кишечника;
- заболевания, связанные с частым мочеиспусканием (например, хроническая сердечная недостаточность);
- прием лекарств, которые уменьшают количество фолиевой кислоты или затрудняют ее всасывание. К ним относятся противосудорожные препараты;
- повышенная потребность в витамине. Беременность, онкологические заболевания, некоторые нарушения кроветворения (к примеру, серповидноклеточная анемия), инфекции – это состояния, которые увеличивают потребность организма в фолиевой кислоте. Недоношенные дети (рожденные до 37-й недели беременности) также нуждаются в большем её количестве.
Симптомы и признаки фолиеводефицитной анемии
Снижение количества эритроцитов приводит к невозможности адекватного снабжения клеток кислородом: слизистые оболочки и кожа бледнеют, человек быстро устает, чувствует себя слабым, возможны обмороки, головокружения, потеря аппетита и похудение. Компенсируя недостаток кислорода, сердце бьётся чаще, чтобы перекачивать кровь быстрее; дыхание ускоряется. Сердцебиение становится ощутимым, появляется одышка. Фолиеводефицитная анемия может сопровождаться поносом, потерей вкуса, онемением конечностей, мышечной слабостью и депрессией.
Виды анемии
Железодефицитная анемия
ЖДА — синдром, при котором снижается запас железа в организме и нарушается синтез железосодержащих белков. Этот вид анемии очень распространен, встречается как у взрослых, так и у детей. Проявляется снижением концентрации гемоглобина и трофичекими расстройствами в тканях. особенно от недостатка кислорода страдает головной мозг.
Симптомы на начальных этапах ни в коем случае нельзя игнорировать!
Если вдруг на протяжении некоторого времении появились перечисленные симптомы, то это серьезный повод обратиться к врачу-терапевту:
- постоянную слабость
- снижение работоспособности
- повышенную утомляемость
- бледность сухость кожи
На первый взгляд совсем безобидные симптомы могут привести к развитию серьезного заболевания и нанести существенный ущерб.
Нормой для взрослого человека является содержание до 5 г железа.
Состояние железодефицита провоцируется такими состояниями:
- хроническая и острая кровопотеря
- диеты и голодания
- заболевания ЖКТ
- беременность, лактация
- физические нагрузки, спорт
Если не обращаться за помощью к специалистам, то с течением времени симптоматика расширяется:
- кожа становится бледной с зеленоватым оттенком, становится дряблой, сухой; волосы становятся сухими, ломкими, быстро седеют, начинают выпадать;
- ногтевые пластины становятся тонкими, плоскими, могут приобретать вогнутую форму;
- характерный признак только для ЖДА — мышечная слабость!
Диагностика железодефицита
Необходима полная лабораторная диагностика:
- анализ крови (общий и биохимический),
- консультация узкого специалиста: гинеколога, уролога, проктолога, гематолога
- возможно даже потребуется пункция костного мозга.
После диагностических мероприятий врач-терапевт назначает индивидуальную схему лечения, которое проводится продолжительное время препаратами железа. Лечебные дозировки назначаются до нормализации уровня гемоглобина, затем пациента переводят на профилактические дозы.
Современные исследования показали, что соблюдение диеты с легкой степенью ЖДА может нормализовать показатели крови и избежать приема препаратов железа. Следует включить в рацион продукты с высоким содержанием белка и железа: печень, говяжий язык, телятина, индейка, красная морская рыба, яйца, гречневая крупа, персики, хурма, яблоки. следует исключить молочные продукты и чай, т.к. они препятствуют всасыванию железа.
Внимательно относитесь к своему здоровью, обращайтесь к опытным специалистам, ведь правильно поставленный диагноз — залог успешного лечения заболевания! Берегите себя и будьте здоровы!
Методы диагностики
Врач может заподозрить анемию по симптомам и результатам общего анализа крови, который покажет сниженное количество эритроцитов. Для подтверждения диагноза необходимо исследовать кровь на содержание фолиевой кислоты и витамина B12, недостаток которого часто сопровождает дефицит B9.
Мало диагностировать заболевание, важно установить его причину. Ведь от этого будет зависеть дальнейшая стратегия лечения. Требуется изучить истории болезни (возможны ли плохое питание, алкоголизм, беременность?) и обследовать пациента на патологии кишечника, печени, сердца.
Прогноз и профилактика
Своевременное лечение В12-дефицитной анемии в большинстве случаев позволяет полностью устранить гематологическое нарушение. Уже на 4−5 сутки можно обнаружить изменения в результатах анализов, рост гемоглобина, количества эритроцитов наблюдается на 7 день. Полностью нормализуются эти показатели через 8 недель.
Неврологические симптомы могут проходить довольно долгое время, до полугода. Повреждения спинного мозга, связанные с анемией, необратимы, поэтому очень важно своевременно обратиться к врачу: гематологу или терапевту.
Повышенное внимание профилактике этого недуга нужно уделять пациентам, которые перенесли бариатрические операции, гастрэктомию. В группе риска вегетарианцы, люди, придерживающиеся строгих диет с ограничением мяса и субпродуктов, беременные и недавно родившие женщины. Профилактика заключается в применении препарата В12 в форме таблеток или инъекций, врач подберет профилактическую безопасную дозу.
Лечение
Начинают с назначения препаратов фолиевой кислоты. Для беременных чаще всего это единственное назначение. В остальных случаях схема терапии составляется с учетом причин заболевания. При несбалансированном питании необходимо пересмотреть рацион и включить в него пищу, богатую витамином В9. Отказ от злоупотребления алкоголем — также важный шаг в борьбе с фолиеводефицитным малокровием.
Проблемы с внутренними органами требуют специфического лечения, в зависимости от типа заболевания.
При низком содержании в крови витамина B12 пациенту назначают его инъекции или таблетки. Это очень важно, поскольку нормализация уровня фолиевой кислоты может маскировать симптомы дефицита B12, способного вызвать нарушения функций нервной системы.
Осложнения заболевания
Течение фолиеводефицитной анемии может осложняться:
- пернициозной (злокачественной) анемией, вызванной недостатком витамина B12;
- лейкопенией (снижением количества лейкоцитов);
- тромбоцитопенией (снижением количества тромбоцитов);
- стоматитом;
- глосситом (воспалением языка);
- тошнотой и рвотой;
- поносом;
- незначительным повышением температуры тела;
- снижением иммунитета.
Фолиеводефицитная анемия и беременность
Недостаток фолиевой кислоты в период беременности очень опасен. Он может привести к патологии развития у плода нервной трубки – структуры, из которой формируются головной и спинной мозг. Эти изменения могут спровоцировать выкидыш, смерть новорожденного или паралич его ног. Пагубный эффект дефицита фолиевой кислоты может сказаться на развитии эмбриона в первые недели после зачатия. Поэтому будущим мамам рекомендуют принимать препараты фолиевой кислоты еще на этапе планирования беременности.
Анемии, патология гемостаза, онкогематология
Материалы представлены из учебного пособия РУДН
Анемии. Клиника, диагностика и лечение / Стуклов Н.И., Альпидовский В.К., Огурцов П.П. – М.: ООО «Медицинское информационное агентство», 2013. – 264 с.
Копирование и тиражирование материалов без указания авторов запрещено и преследуется по закону.
Мегалобластные анемии – это макроцитарные анемии, при которых определяется нарушение кроветворения в костном мозге, в виде наличия измененных предшественников эритроцитов – мегалобластов. Мегалобласты – это эритрокариоциты, характеризуются определенными особенностями: крупные, незрелые по внешнему виду, ядра окружены относительно более зрелой цитоплазмой. С биохимической точки зрения, первичным при этом состоянии является нарушение синтеза ДНК: клетки прекращают развиваться в S-фазе клеточного цикла и не могут завершить процесс деления. В результате этого происходит накопление крупных, «ожидающих» митоза клеток и их преждевременная гибель. Чаще всего мегалобластоз обусловлен недостаточностью витамина В12 (,кобаламина) и фолиевой кислоты, а также приемом лекарственных препаратов, ингибирующих синтез ДНК.
Витамин В12 (кобаламин) продуцируется микроорганизмами – обитателями корнеплодов и бобовых, и присутствует в мышцах и паренхиматозных органах животных, питающихся этими растениями. Человек получает кобаламин с животной пищей. Общее содержание кобаламина в организме человека составляет 2 – 5 мг, а поскольку ежедневная его потеря очень невелика (2 – 5 мкг/сутки), то в случае полного прекращения поступления витамина, его запасов (в основном в печени) хватит на 3 – 5 лет.
Для усвоения витамина В12 необходим внутренний фактор (ВФ), который секретируется париетальными клетками желудка. Комплекс кобаламин + ВФ продвигается в дистальные отделы подвздошной кишки, где кобаламин абсорбируется. В крови кобаламин связывается с транскобаламином II – транспортным белком, который осуществляет доставку кобаламина к тканям-мишеням. 1% кобаламина всасывается без образования комплекса с внутренним фактором.
Фолаты (витамины группы В) содержатся в листовых овощах (бобовые, салат, шпинат), фруктах, грибах, животных белках. Запасы фолатов в организме человека равны 5 – 10 мг, а их суточная потеря – 100 — 200 мкг, поэтому полное прекращение поступления фолатов приводит к их дефициту через 1 – 2 месяца. Всасываются фолаты тоже в дистальных отделах тонкого кишечника.
Основные клинические проявления и их патогенез
В мегалобластный процесс вовлекаются все делящиеся клетки, однако наиболее страдают активно пролиферирующие клеточные системы, такие как костный мозг и эпителий. Это определяет преобладание в клинике анемии симптомов, связанных с нарушением кроветворения и поражением слизистой желудочно-кишечного тракта. Кроме того, при дефиците витамина В12происходит ряд нарушений со стороны центральной и периферической нервной системы, которые никогда не наблюдаются при дефиците фолатов.
В костном мозге при дефиците витамина В12 и фолатов происходит замена нормобластического кроветворения мегалобластическим, которое характеризуется нарушением пролиферации и дифференцировки кроветворных элементов и внутрикостномозговой гибелью большинства ядросодержащих клеток красного ряда (неэффективный эритропоэз), а также нарушением вызревания гранулоцитов и мегакариоцитов. Все это неизбежно приводит к развитию макроцитарной анемии (т.к. часть мегалобластов все же вызревает до зрелых форм – макроцитов), которая сопровождается гранулоцитопенией и тромбоцитопенией.
Поскольку анемия при дефиците витамина В12 и фолиевой кислоты развивается постепенно, в течение длительного времени, больные обычно неплохо адаптированы к низкому уровню гемоглобина.
Помимо общих симптомов анемии возможен лимонный оттенок кожи – сочетание бледности и желтухи, которая является с одной стороны следствием неэффективного эритропоэза (внутрикостномозгового распада гемоглобинсодержащих мегалобластов), с другой непрямой билирубинемией, связанной с повышенным гемолизом крупных форм эритроцитов (мегалоцитов) в селезенке. При мегалобластной анемии часто имеется усиление пигментации ногтевого ложа и кожных складок. Может развиваться умеренная спленомегалия как результат экстрамедуллярного гемопоэза.
Нарушение деления эпителиальных клеток при мегалобластных анемиях приводит к появлению атипичных митозов и гигантских клеток на слизистых оболочках языка, полости рта, пищевода, желудка и кишечника. При этом слущивающиеся эпителиальные клетки не восстанавливаются, что приводит к воспалительно-атрофическим изменениям слизистой, которые клинически проявляются в виде глоссита, стоматита, эзофагита, гастрита и энтерита. Для типичной картины глоссита Хантера свойственно появление ярко-красных участков воспаления на кончике и по краю языка, иногда захватывающих всю его поверхность («ошпаренный язык»). Нередко на языке наблюдаются афтозные высыпания и трещины.
Подобные изменения могут распространяться на десны, слизистую щек, мягкое небо, глотку и пищевод. Прием пищи и лекарственных средств сопровождаются ощущением жжения и болью. Иногда больные жалуются на чувство тяжести в эпигастральной области, потерю аппетита и расстройство стула. Кроме нарушения функции костного мозга и целостности слизистой, дефицит витамина В12 (но не фолиевой кислоты!) вызывает неврологическую патологию, для которой характерна пятнистая демиелинизация серого вещества в головном и спинном мозге и периферических нервах. Предполагается, что недостаток витамина В12 приводит к угнетению метаболизма жирных кислот, в результате чего происходит внедрение аномальных жирных кислот в миелин и его разрушение.
Неврологические симптомы дефицита витамина В12 различны в зависимости от тяжести патологии. К ранним признакам относится дисфункция задних рогов спинного мозга с потерей проприоцепции и ощущения вибрации. Пациенты двигаются с трудом, широко расставляя ноги при ходьбе. Позже у них развивается поражение пирамидного, спино-мозжечкового и спиноталамического трактов, сопровождающиеся мышечной слабостью, прогрессирующей мышечной спастичностью, гиперрефлексией, ножницеобразной походкой. Возможно также повреждение периферических нервов с утратой глубоких сухожильных рефлексов, параличом черепно-мозговых нервов, потерей контроля над сфинктерами. При длительном дефиците витамина В12 возникает деменция и нейропсихические заболевания. Неврологическая симптоматика при дефиците витамина В12 может иметь место и без анемии.
Лабораторные данные
Мегалобластные анемии являются макроцитарными и нормохромными. При просмотре мазков крови определяется выраженный макроцитоз с наличием интенсивно окрашенных мегалоцитов, а иногда – мегалобластов (рис. 29), и пойкилоцитоз. Нередко встречаются шизоциты и эритроциты с остатками ядер в виде колец Кебота и телец Хавелл-Жолли. Количество ретикулоцитов уменьшено. Число лейкоцитов обычно снижено. Характерен левый сдвиг в лейкограмме до миелоцитов и присутствие гигантских нейтрофилов с гиперсегментированным ядром (до 6 – 8 сегментов вместо обычных трех). Число тромбоцитов, как правило, не превышает 100х109/л, иногда наблюдается глубокая тромбоцитопения.
В костном мозге, который обычно гиперклеточный, наблюдается преобладание клеток эритроидного ростка («синий костный мозг», рис 33), мегалобластический эритропоэз, с характерной структурой хроматина эритробластов (шагреневость ядер), большое количество митозов (рис. 34), многоядерных мегалобластов и наличие гигантских элементов гранулоцитарного рядаи атипичных мегакариоцитов с нарушенной отшнуровкой тромбоцитов.
Продолжительность жизни эритроцитов при мегалобластной анемии укорочена до 27– 75 дней. Повышенная деструкция циркулирующих мегалоцитов и мегалобластов в костном мозге приводит к увеличению содержания в плазме неконъюгированного (непрямого, несвязанного) билирубина. Уровень железа сыворотки и содержание гемосидерина в костном мозге обычно повышены.
Характерным для мегалобластной анемии является увеличение в сыворотке активности лактатдегидрогеназы (ЛДГ), в основном за счет изоэнзимов ЛДГ-1 и ЛДГ-2, которая связана с попаданием в кровь большого количества молочной кислоты и отражает повышенную деструкцию мегалобластов в костном мозге и мегалоцитов в периферической крови.
Диагностика
Дефицит витамина В12 наиболее достоверно устанавливается по низкому уровню витамина В12 в сыворотке (менее 160 нг/л). В клинической практике надежным диагностическим тестом дефицита витамина В12 служит положительный ответ в виде ретикулоцитарного криза на введение витамина В12.
Критерием фолиевой недостаточности является низкий уровень фолатов (менее 2,5 мкг/л) при нормальном содержании в сыворотке витамина В12 и нормальной его абсорбции. Диагностическим тестом фолиеводефицитной природы мегалобластной анемии может рассматриваться развитие гематологической ремиссии после лечения фолиевой кислотой (по 2 мг/сутки), которая невозможна при недостаточности витамина В12.
В клинической практике наиболее часто (около 90% случаев) приходится иметь дело с мегалобластной анемией, обусловленной дефицитом витамина В12 и значительно реже – недостаточностью фолатов, однако существуют и смешанные формы (при синдроме нарушенного всасывания). В зависимости от патогенетических механизмов, вызывающих развитие дефицита витамина В12 или фолатов, все мегалобластные анемии разделяются на 4 группы:
1. вследствие сниженного поступления с пищей;
2. вследствие нарушения абсорбции;
3. вследствие нарушенного транспорта и метаболизма;
4. вследствие повышенного потребления.
Дифференциальный диагноз
Мегалобластический эритропоэз наблюдается при миелодиспластическом синдроме. При этом, помимо мегалобластных изменений, наблюдаются и другие признаки дисэритропоэза: двуядерные эритробласты, нарушения гемоглобинизации и наличие «мостиков» между эритробластами. В этом случае отсутствует эффект от терапии витамином В12 и фолиевой кислотой.
Мегалобластоз и созревание эритроцитов причудливой формы характерны для картины костномозгового кроветворения при остром эритромиелозе (синдроме Ди Гульельмо), однако, при этом заболевании обычно имеется увеличенное содержание в миелограмме бластных клеток. Терапия витамином В12 при остром эритромиелозе также неэффективна.
Мегалобластные анемии приходится дифференцировать с другими макроцитарными анемиями, при которых обнаруживается нормобластическое кроветворение. Немегалобластический макроцитоз при алкоголизме обычно связан с патологией липидов, увеличивающих размер эритроцитарной мембраны. Такой же механизм возможен при заболеваниях печени и тиреотоксикозе. Алкогольный макроцитоз наблюдается у всех больных, злоупотребляющих алкоголем, причем макроцитоз сохраняется в течение всего жизненного цикла эритроцитов, в течение длительного времени после полного прекращения приема алкоголя. Увеличение среднего объема эритроцитов, выявляемое с помощью гематологического анализатора, наблюдается у больных с ретикулоцитозом, поскольку ретикулоциты крупнее зрелых эритроцитов. В отличие от мегалобластного истинного макроцитоза, при котором содержание ретикулоцитов снижено, макроцитоз из-за ретикулоцитоза сопровождается либо симптомами гемолиза, либо признаками острой кровопотери.
Патогенетическая классификация мегалобластных анемий, обусловленных дефицитом витамина В12 или фолатов
I. Вследствие сниженного поступления с пищей (чаще — фолиеводефицитные):
1. нутритивные мегалобластные анемии;
2. мегалобластные анемии алкоголиков.
II. Вследствие нарушенной абсорбции:
1. мегалобластные анемии, обусловленные недостаточной секрецией внутреннего фактора – пернициозная анемия и мегалобластная анемия при тотальной и субтотальной резекции желудка (В12-дефицитные);
2. мегалобластные анемии при заболеваниях тонкого кишечника (спру и идиопатической стеаторее) и его анатомической недостаточности (фолиеводефицитные);
3. мегалобластные анемии, обусловленные повышенным конкурирующим потреблением: при синдроме слепой петли, дивертикулах кишечника и глистной инвазии широким лентецом (В12-дефицитные).
III. Вследствие нарушения транспорта и метаболизма:
1. мегалобластные анемии при приеме противосудорожных препаратов и антагонистов фолиевой кислоты (фолиеводефицитные);
2. мегалобластные анемии при заболеваниях печени (витамин В12-дефицитные).
IV. Вследствие повышенного потребления:
1. мегалобластная анемия беременных;
2. мегалобластные изменения при гемолитических анемиях, опухолях, лейкозах (фолиеводефицитные).
Мегалобластные анемии вследствие сниженного поступления с пищей витамина В12 или фолатов (нутритивные)
Нутритивные мегалобластные анемии, обусловленные недостатком в пище витамина В12, встречаются очень редко. Этот тип анемий описан среди людей, которые поддерживаются строго вегетарианской диеты, исключающей использование каких-либо продуктов животного происхождения. В подавляющем большинстве случаев нутритивные мегалобластные анемии вызваны нехваткой в пище фолатов, которые, хотя и широко распространены в продуктах питания, легко разрушаются под воздействием света и тепловой обработке пищи. Кроме того, запасы фолатов в организме сравнительно невелики, а в обычной пище их содержание лишь незначительно превышает дневную потребность.
Нутритивная фолиеводефицитная мегалобластная анемия наблюдается у хронических алкоголиков, представителей беднейших слоев населения, чье питание лишено овощей, мяса, яиц и молока; у новорожденных, чаще недоношенных, при вскармливании только коровьим и козьим молоком и у детей, получающих синтетическую диету по поводу фенилкетонурии.
Этот тип анемий распространен также среди жителей некоторых районов Юго-Восточной Азии и Африки, диета которых включает незначительно количество мяса и овощей, а основные пищевые продукты (рис и бананы) подвергаются длительной тепловой обработке. Нутритивные мегалобластные анемии часто протекают с симптомами глоссита и эзофагита, однако, поражение нервной системы, как правило, отсутствует.
Лечение нутритивной мегалобластной анемии состоит в назначении диеты, богатой фолатами, и приеме фолиевой кислоты (по 1-2 мг/сутки), а также витаминов С, В1, В6, В2, РР и др., поскольку дефицит фолатов часто сочетается с недостаточностью других витаминов.
Мегалобластные анемии, обусловленные нарушением абсорбции витамина В12 или фолатов
Нарушение абсорбции витамина В12 наиболее часто вызвано дефицитом в желудочном соке внутреннего фактора (ВФ), который может быть следствием нарушения секреции ВФ слизистой фундального отдела желудка или его отсутствием при тотальной (субтотальной) резекции желудка.
Нарушение секреции ВФ лежит в основе так называемой злокачественной или пернициозной анемии (болезни Аддисон-Бирмера). Это заболевание, впервые описанное Аддисоном в 1855 году и до 20-х годов XX века неизбежно заканчивавшееся летально (отсюда и название – пернициозная анемия), наблюдается в основном среди пожилых людей, но может наблюдаться у лиц любого возраста. Более высокая заболеваемость пернициозной анемией среди жителей Скандинавских стран и афроамериканцев, высокая частота группы крови А у больных и их родственников и нередко семейный характер болезни указывают на возможное участие генетических факторов в патогенезе «злокачественного» малокровия. Общая частота заболеваемости 25:100000 человек в год среди людей старше 40 лет.
Однако, главная роль в развитии пернициозной анемии несомненно принадлежит аутоиммунным механизмам: у 90% больных в сыворотке и желудочном соке обнаруживаются антитела против клеток слизистой желудка, а у 60% больных – антитела против ВФ или комплекса ВФ-витамин В12.
Клиническая картина болезни Аддисон-Бирмера складывается из симптомов, связанных с анемией, признаков поражения слизистой желудочно-кишечного тракта, неврологических и психических симптомов, патогномоничным является наличие хронического гастрита с гистаминоустойчивой ахлоргидрией.
Диагностика пернициозной анемии основывается на анамнестических данных (нередко семейный характер заболевания), обнаружении характерных для мегалобластной анемии изменений в крови и костном мозге, наличии ахлоргидрии, устойчивой к стимуляции гистамином, лабораторных и клинических признаках дефицита витамина В12 (низкий уровень витамина В12 в сыворотке и ответ на терапию витамином В12), положительных результатов теста Шиллинга.
Тест Шиллинга используется для оценки абсорбции в кишечнике меченого 57Со витамина В12. Больному дается 0,5-2,0 мкг радиоактивного витамина В12 per os, а затем через 2 часа в/м вводится 1000 мкг нерадиоактивного витамина В12 для насыщения транскобаламина. С момента приема меченого витамина В12 собирается суточная моча.
У здоровых людей с мочой в течение суток выделяется ≥ 7% полученной радиоактивности, а у больных с нарушенной абсорбцией витамина В12 — менее 5% (при пернициозной анемии этот показатель обычно менее 2%).
При недостаточной продукции ВФ его добавление к меченному 57Со витамину В12, по крайней мере, в 5 раз повышает радиоактивность суточной мочи. Напротив, экскреция радиоактивного витамина В12 существенно не изменяется при нарушении абсорбции витамина В12, не связанной с дефицитом ВФ.
Хотя в большинстве случаев пернициозную анемию можно диагностировать без радиоизотопного исследования, тест Шиллинга позволяет выявить скрытые формы этого заболевания у леченых больных и у больных с витамин В12-дефицитными нейропатиями или психозами, у которых после неадекватной терапии мегалобластные изменения в костном мозге могут отсутствовать, а неврологические нарушения – сохраняться.
Мегалобластная анемия после тотальной или субтотальной резекции желудка обычно развивается через 3-5 лет после оперативного вмешательства. При значительном сходстве с болезнью Аддисон-Бирмера для агастральной мегалобластной анемии характерна меньшая выраженность симптомов гемолиза и отсутствие гиперсидеринемии. Нередко снижение уровня железа сыворотки, связанное с нарушением всасывания пищевого железа, особенно при демпинг-синдроме, у больных с резецированным желудком оказывается столь значительным, что маскирует свойственные мегалобластной анемии изменения в костном мозге, которые выявляются после терапии препаратами железа.
Лечение мегалобластных анемий, вызванных недостаточной секрецией ВФ, состоит во в/м введении витамина В12 в дозе 1000 мкг ежедневно в течение 2-х недель, а затем – еженедельно до наступления клинико-гематологической ремиссии, характеризующейся исчезновением всех симптомов заболевания, за исключением гистаминоустойчивой ахлоргидрии, которая сохраняется и в период ремиссии.
После введения витамина В12, через 24-72 ч, происходит трансформация мегалобластического кроветворения в нормобластическое, а к 5-6 дню в крови увеличивается число эритроцитов за счет поступления в циркуляцию незрелых форм (ретикулоцитарный криз). Довольно быстро исчезают диспепсические явления и глоссит. Наиболее устойчивы к лечению неврологические поражения, поэтому при фуникулярном миелозе введение 1000 мкг витамина В12 следует продолжить после нормализации гематологических показателей, а далее – 1 раз в 2 недели в течение 6 месяцев. Для поддержания клинико-гематологических ремиссий больные пернициозной и агастрической мегалобластной анемией нуждаются в пожизненном лечении витамином В12 (по 500 мкг 1-2 раза в месяц в/м) или в комплексе с ВФ (30 мкг витамина В12 и 50 мг ВФ per os 1 раз в неделю).
Переливание крови или эритроцитарной массы показано только при пернициозной анемической коме, которая развивается при очень низком уровне гемоглобина и может угрожать жизни больного из-за нарастающей гипоксемии. Назначение фолиевой кислоты при дефиците витамина В12 нецелесообразно. Препараты железа дают только при сочетании мегалобластной анемии с дефицитом железа.
Мегалобластные анемии вследствие тонкокишечной патологии носят, как правило, фолиеводефицитный характер, поскольку запасы фолиевой кислоты по сравнению с витамином В12 ограничены. Фолиеводефицитные мегалобластные анемии наблюдаются при затяжных энтеритах (спру и идиопатической стеаторее), при органических поражениях тонкого кишечника (полипоз, лимфоматоз, лейкемическая инфильтрация и образование стриктур), при резекции обширного участка тонкого кишечника, при желудочно-тонкокишечном свище.
Помимо нарушения всасывания фолатов существенную роль в развитии мегалобластных анэнтеральных анемий играет дисбактериоз, в результате которого нарушается биосинтез фолатов мочекислыми бактериями. Кроме дисбактериоза развитию мегалобластной анемии способствует появление в тонком кишечнике атипичной флоры (чаще – кишечной палочки), конкурирующей с макроорганизмом в отношении использования витамина В12. Этот механизм может лежать в основе мегалобластной анемии при синдроме слепой петли и дивертикулах тонкого кишечника.
При длительном течении болезней тонкого кишечника и недостаточности фолатов присоединяются дефициты витамина В12 и железа, белковая, минеральная и поливитаминная недостаточность.
Лечение анэнтеральных мегалобластных анемий включает борьбу с основным заболеванием и назначение фолиевой кислоты в сочетании с поливитаминами.
Помимо заболеваний, способствующих появлению атипичной бактериальной флоры в тонком кишечнике, конкуренция с макроорганизмом в отношении витамина В12 имеет место при инвазии широким лентецом, который наиболее часто встречается в Скандинавских странах, в районе Великих озер Северной Америки и некоторых озер на границе Швейцарии и Франции.
Заражение широким лентецом человека происходит при употреблении в пищу недостаточно обработанной или сырой рыбы, содержащей предстадии паразита. В тонком кишечнике человека иногда содержится до 3000-4000 особей широкого лентеца, причем длина некоторых из них может достигать 10 метров. Мегалобластная анемия в результате потребления витамина В12 широким лентецом развивается только у 30% носителей этого паразита.
Клиническая картина глистной мегалобластной анемии в зависимости от количества паразитов в кишечнике варьирует от незначительного макроцитоза до развернутой мегалобластной анемии с неврологическими поражениями. В крови часто определяется эозинофилия.
Длительное пребывание паразита в кишечнике сопровождается также общим истощением и появлением диспепсических расстройств.
Диагностика глистной мегалобластной анемии основывается на обнаружении характерных изменений в крови и костном мозге и яиц широкого лентеца в каловых массах.
Лечение глистной мегалобластной анемии состоит в назначении витамина В12, а по достижении клинико-гематологической ремиссии – в проведении дегельминтизации.
Мегалобластные анемии, обусловленные нарушением транспорта и метаболизма фолатов и витамина В12
Мегалобластическое кроветворение в костном мозге нередко развивается при длительном приеме противосудорожных средств (дифенин, фенобарбитал), применяющихся для лечения эпилепсии. При этом в крови у больных обнаруживается снижение уровня фолатов при нормальной концентрации витамина В12.
Предполагается, что противосудорожные средства нарушают абсорбцию и транспорт фолатов. Не исключено также, что противосудорожные средства нарушают метаболизм фолатов, действуя как их прямые антагонисты. Развернутая картина мегалобластной анемии при приеме противосудорожных средств наблюдается редко и только при сочетании с неадекватным поступлением фолатов с пищей.
Профилактический прием фолиевой кислоты при лечении противосудорожными средствами обычно предотвращает развитие мегалобластных изменений в костном мозге.
Дефицит фолатов развивается также при лечении антифолиевыми цитостатиками (метотрексат).
Макроцитарная анемия описывается при хронических заболеваниях печени и является одним из важнейших показателей тяжести нарушения ее функций. В основе мегалобластных изменений при хронических заболеваниях печени лежит нарушение метаболизма витамина В12, обусловленное снижением его депонирования в печени.
Наряду с приобретенными встречаются наследственные нарушения транспорта и метаболизма витамина В12 и фолатов.
Синдром Иммерслунд-Гресбека характеризуется генетически обусловленным нарушением транспорта витамина В12 через кишечную стенку и устойчивой протеинурией. Секреция ВФ и соляной кислоты при этом заболевании сохранены. Антитела против ВФ отсутствуют.
К нарушению метаболизма витамина В12 приводит также врожденный дефицит транскобаламина II и врожденные энзимопатии, при которых блокируется конверсия витамина В12 в коэнзимные формы.
Нарушение метаболизации фолатов наблюдается при наследственном дефиците гемоцистеин-5-метилтетрагидрофолатметилтрансферазы и синдроме Леш-Нахана (дефицит гипоксантингуанинфосфорибозил-трансферазы), характеризующимся гиперурикемией и повышенным синтезом пуринов.
У детей с наследственным нарушением транспорта и метаболизма фолатов мегалобластная анемия развивается уже в возрасте 3 мес. Первые симптомы наследственной недостаточности витамина В12 могут появиться после 6 мес., но обычно они обнаруживаются к 3-му году жизни.
Мегалобластные анемии, обусловленные повышенным потреблением витамина В12или фолатов
Анемия является одним из наиболее распространенных осложнений беременности. В большинстве случаев развитие анемии у беременных женщин зависит от нескольких факторов: значительного увеличения объема циркулирующей плазмы, дефицита железа и фолатов. Чистая мегалобластная анемия вследствие недостаточности фолатов встречается довольно редко: у 1/5-1/6 беременных с уровнем гемоглобина 95 г/л.
Развитие дефицита фолатов при беременности обусловлено 4-10-кратным увеличением ежедневной потребности фолатов, особенно в последнем триместре, при их относительно небольших запасах в организме.
Многоплодие, недостаточное питание (часто в результате тошноты и рвоты), инфекции, развитие гемолитической анемии или прием противосудорожных средств увеличивают потребность в фолатах. Лактация также значительно усугубляет существующий в организме дефицит фолатов. Учитывая возможное развитие дефицита фолатов при беременности, который может сочетаться такими осложнениями, как отслойка плаценты, спонтанные выкидыши и кровоточивость, незаращение нервной трубки плода, рекомендуется назначение фолиевой кислоты всем беременным женщинам в дозе 5 мг/день.
Для лечения фолиеводефицитной анемии беременных необходимы большие дозы фолиевой кислоты (не менее 0,1 г в день).
Дефицит витамина В12 при беременности развивается чрезвычайно редко, поскольку его запасы в организме достаточно велики. Сочетание болезни Аддисон-Бирмера и беременности, при котором последняя может сопровождаться развитием мегалобластной анемии, практически исключено, поскольку пернициозной анемией болеют в основном люди пожилого возраста.
Мегалобластные изменения в костном мозге вследствие повышенного потребления фолатов могут наблюдаться при гемолитических анемиях с выраженной нормобластной гиперплазией, метастатических опухолях и лейкозах. Уровень фолатов в плазме при этих заболеваниях может не изменяться, поскольку их повышенное потребление осуществляется на уровне костного мозга интенсивно пролиферирующими эритро- и нормобластами, опухолевыми и лейкозными клетками.
При наличии мегалобластных изменений в костном мозге назначение фолатов показано больным с гемолитическими анемиями и больным с неоплазмами. Вопреки сложившимся представлениям установлено, что прием фолиевой кислоты не ухудшает течения хронического миелолейкоза и острого миелобластного лейкоза.
Дефицит фолатов наблюдается также и у больных с эксфолиативными дерматитами, поскольку со слущивающимся эпителием теряется до 5-20 мкг фолатов в день. Профилактическое назначение фолиевой кислоты больным с эксфолиативными дерматитами предотвращает развитие мегалобластной анемии.
Мегалобластные анемии, не связанные с дефицитом витаминаВ12 или фолатов
Мегалобластные анемии иногда могут развиваться при нормальном уровне витамина В12 и фолатов в сыворотке. Мегалобластные анемии, обусловленные нарушением синтеза ДНК, который не связан с дефицитом витамина В12 или фолатов, наблюдается:
1. при лечении антиметаболитами (6-меркаптопурин, тиогуанин, азатиоприн и др.), ингибирующими синтез пуринов, пиримидинов и других нуклеотидов;
2. при наследственных нарушениях метаболизма (врожденной оротовой ацидурии и наследственном дефиците форминотрансферазы);
3. при состояниях с неустановленным патогенезом: пиридоксин — чувствительной и рефрактерной сидеробластной анемии и эритремическом миелозе или синдроме Ди Гульельмо.